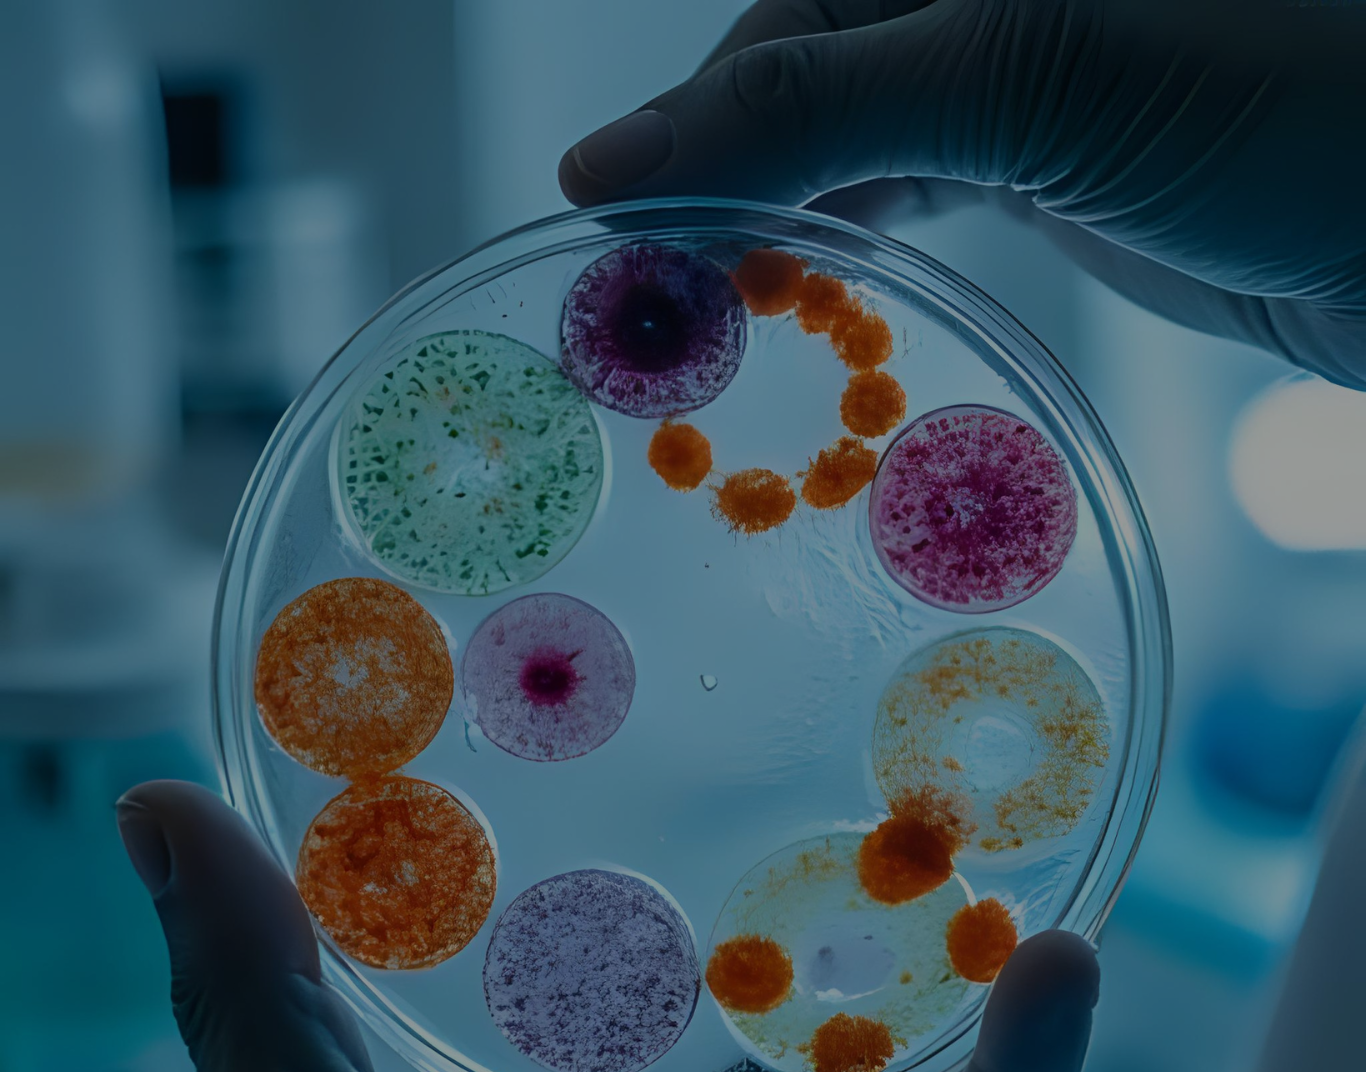
THE AMAZING SLIDESHOW ADDON!

Adakah anda sedang mencari perkhidmatan analisis dan makmal khusus?
Menjana Inovasi Sains, Menerajui Kecemerlangan.
Memperkasakan PIPS dalam melaksanakan tanggungjawab dengan memenuhi piawaian yang diiktiraf sebagai pusat pengujian dan perkhidmatan.
Menyediakan Instrumen
Berspesifikasi Tinggi
Terokai Perkhidmatan Kami
Di PIPS, kami mengutamakan kecemerlangan dalam penyelidikan, inovasi, serta perkhidmatan instrumentasi dan ujian saintifik bertaraf tinggi yang menyokong pelbagai disiplin, termasuk sains bahan, kajian alam sekitar, bioteknologi, kejuruteraan, dan sebagainya.
Capaian Perkhidmatan Makmal Bersepadu PIPS
0
Sejak tahun
0
Bilangan permohonan
0
Bilangan sampel yang dianalisis
Pengurusan pelupusan sisa buangan terjadual PIPS
Pengurusan sisa buangan terjadual PIPS
Sisa Kimia (12 April 2022-11 April 2025)
Sisa Kimia (12 April 2022-11 April 2025)
0
Kutipan fasa 1
22-27 April 2022
22-27 April 2022
0
Kutipan fasa 2
15 Mei-13 Jun 2023
15 Mei-13 Jun 2023
0
Kutipan fasa 3
20-24 Jun 2024
20-24 Jun 2024
Pengurusan sisa buangan terjadual KLINIKAL
berpusat di 5 FAPI (2024-2026)
berpusat di 5 FAPI (2024-2026)
0
Kutipan fasa 1
4 Julai 2024
4 Julai 2024
0
Kutipan fasa 2
-
-
0
Kutipan fasa 3
-
-